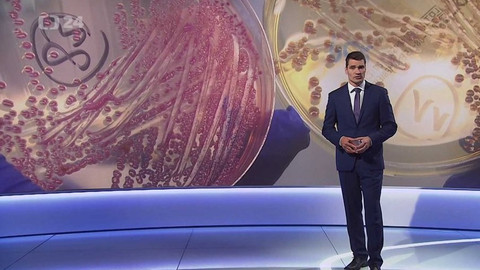
Věda 24 - 9. června 2019

2. června 2019
Obsah dílu
Nové metody při operacích mozkových nádorů — Záhadná zemětřesení v Indickém oceánu — Restaurování rukopisných plánů z 18. století — Dopady tzv. protikuřáckého zákona — Vesmírný inkubátor Evropské kosmické agentury — Archeologický výzkum v kostnici u Kutné Hory — Globální problém hadích uštknutí — Speciální lepidlo na zlomené kosti — Skladba Antonína Dvořáka pod taktovkou umělé inteligence — Ručník z ISS
Části dílu

Přehled dílů

1. února
ČSÚ zjišťoval, jak žijí děti ve věku 9 až 15 let — AI mění videa tak, že jim uvěříte — Připomínka osudů Židů díky interaktivní mapě MemoMap — Vědecký výzkum: jak lidi prožívají operu — Soutěž Ocean Art Underwater Photography — Lidé berou stále více léků a některé kombinace mohou škodit — Návrat lidí k Měsíci po více než 50 letech — 40 let od tragédie raketoplánu Challenger — Hyde Park Civilizace: Radek Kaiser — Chronický únavový syndrom — Věda kolem nás: proč tučňákům nemrznou nohy — Vědci našli na Moravě bílý buk

25. ledna
Rytina koně z doby ledové se našla v Moravském krasu — Užívání paracetamolu v těhotenství a souvislost s autismem — Smlouva o volném moři k ochraně oceánů — Ceny Neuron — Zemřel lékař Jiří Šnajdauf — Už za dva týdny by se mohli lidé vrátit k Měsíci — Jak zní dávno mrtvé jazyky — Odkrytí vraku možná největší středověké obchodní lodi — Nebe nad Českem rozsvítila polární záře — Hyde Park Civilizace: Josef Salomonovič — Věda online — Jak se připravit na riziko pádu laviny — Věda kolem nás: jak se učit efektivně — Kráva, která se umí drbat koštětem

18. ledna
Léčba přizpůsobená konkrétnímu pacientovi se vzácnou nemocí pomocí metody CRISPR — Nejistá budoucnost miliardové investice na podporu vývoje infrastruktury pro AI — Raketové palivo z rakety Falcon 9 viditelné z Česka — Posádka mise Crew-11 úspěšně přistála na Zemi — Psychedelika jako možná prevence infarktu — Věda online — Hyde Park Civilizace: rok Donalda Trumpa ve vědě — Výzkum vesmíru v letošním roce — Věda kolem nás: proč je na horách velká zima? — 25 let Wikipedie — 30. výročí objevení planetky Járacimrman — Palubní lístek na misi Artemis II

11. ledna
Předčasný návrat posádky z ISS kvůli zdravotním problémům — Možná nejstarší důkaz chůze po dvou u předchůdců člověka — Lipno pokryl zelený led — Ptačí hodinka — Veletrh CES v Las Vegas — Hlavní témata ve světě vědy v letošním roce — Češi byli loni opět světoví — Hyde Park Civilizace: jakou společnost uvidíme za 10 let – Ladislav Dušek — Věda online — Věda kolem nás: mráz a vliv na lidské tělo — Astronomické jevy v roce 2026

21. prosince 2025
NASA má nového administrátora — Evropa míří k zákazu tzv. věčných chemikálií — Výskyt lepry v Evropě — Teplotní inverze v Česku — 10 let od úspěšného přistání nosné rakety Falcon 9 — Začíná astronomická zima — Věda online — Hyde Par Civilizace v roce 2025 — Nový systém na pomoc záchranářům a armádě — Věda kolem nás: kypřicí prášek do těsta — Statistika ohledně vánočních stromků a rychlost pohybu Ježíška

14. prosince 2025
Přibývá satelitů a komplikuje to vesmírná pozorování — Česko je na prahu chřipkové epidemie — Málo státních peněz na českou vědu — Kočka divoká se vrací do české krajiny — Předávání Nobelových cen, oceněni byli i tvůrci AI — Lidé ovládli oheň o 350 000 let dřív, než se předpokládalo — Věda online — Počasí na Vánoce — Hyde Park Civilizace: Karl Bushby – pěšky kolem světa — Věda kolem nás: časy východů a západů Slunce — Chobotnice hrající na piano

7. prosince 2025
NASA našla cukry ve vzorcích z asteroidu Benu — Americká léková agentura chce zpřísnit schvalování vakcín — Vědci z AV ČR popsali proces, jak probíhá první fáze infekce lymské boreliózy — Vědci v praxi ověřili, jak mohl vypadat pravěký lov — Konference Quantum Day 2025 zaměřující se na využití kvantových technologií — Věda online — Hyde Park Civilizace: sociální psycholožka Iva Poláčková Šolcová — Výzkum přírody na antarktickém ostrově Jamese Rosse — Olympijská pochodeň — Zákony robotiky Isaaca Asimova — Věda kolem nás: mikrovlnná trouba — Adventní kalendář vánočních zajímavostí

30. listopadu 2025
Mozkový implantát testuje další firma — Žloutenka typu A se v Česku dál šíří — Se šířením virů a bakterií pomáhají desinfekční prostředky — Otazník nad dalšími ruskými pilotovanými lety do kosmu — S obnovou korálových útesů by mohla pomoct AI — Agrese mezi dětmi v online prostoru narůstá — Jedna z největších zelených stěn v Evropě vznikla nedaleko Prahy — Robotický skener slouží v Kriminalistickém ústavu PČR — Věda online — Před 110 Albert Einstein představil obecnou teorii relativity — Hyde Park Civilizace: Susumu Tonegawa — Věda kolem nás: beton — Pustí lidé v metru sednout těhotnou ženu, nebo Batmana?

23. listopadu 2025
Požár a protesty na konferenci COP30 — Častá konzumace ultrazpracovaných jídel může poškodit zdraví — Čeští vědci objevili nového prvoka — Lidé, kteří se učí nové jazyky, pomaleji stárnou — Hyde Park Civilizace: Tomáš Cihlář — Vyjádření k údajnému vztahu vakcín a autismu — Úspěch studentů z Masarykovy univerzity a Vysokého učení technického — Projekt Otevřená věda Akademie věd ČR — Věda online — 80 let od začátku norimberského procesu — Věda kolem nás: vysílání České televize — Šimpanzi se umí rozhodovat podobně jako lidé

16. listopadu 2025
Nanomateriály mění svět — Předvečer 17. 11. 1989 — Hyde Park Civilizace: listopad 1989 pohledem Václava Malého — Druhý start obří rakety New Glenn — Ceny Technologické agentury ČR — Jak Češi používají internet a AI — Výprava k objasnění původu eukaryotické buňky — Polární záře v Česku — Věda online — Nová interaktivní výstava ESA Země z vesmíru — Satelitní snímky Země jako zdroj zábavy — Věda kolem nás: technický sníh — Taktika drobných pavouků v obraně proti predátorům



